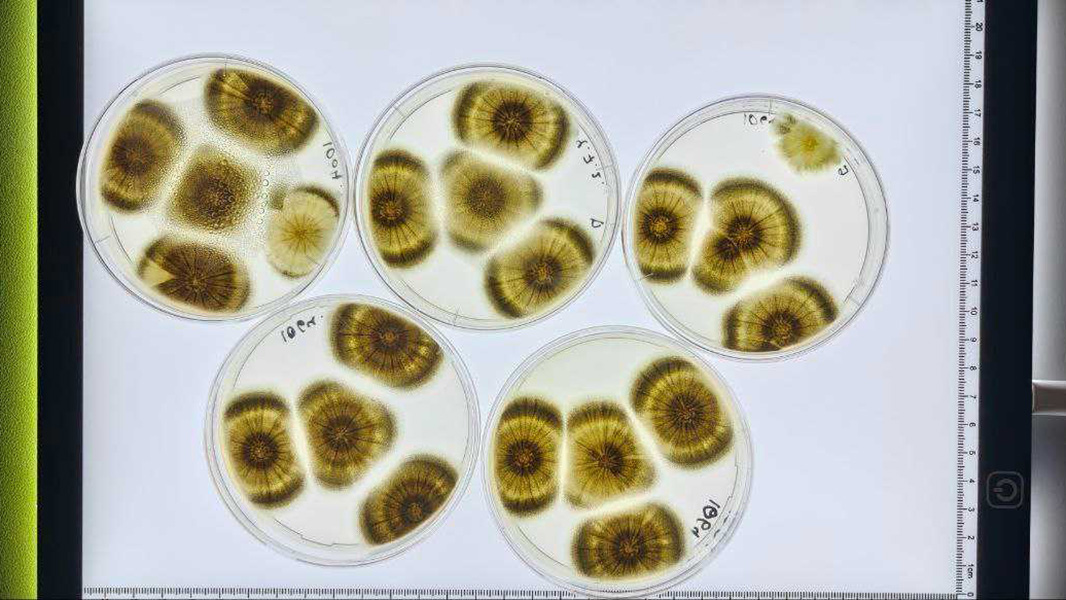

Еда из воздуха и плащ-невидимка: учёный рассказал, чем занимаются биотехнологи
Превращать воздух в еду, придумывать новые микроорганизмы и растения, менять гены и даже создавать плащ-невидимку. Это не колдовство и не магия, а синергия естествознания и программирования. 18 октября профессиональный праздник отмечают специалисты, которые одновременно являются учёными, инженерами, технологами, программистами, химиками и биологами. О тайнах биотеха рассказал «Рамблеру» кандидат химических наук, заведующий лабораторией разработки экспрессионных систем ФИЦ Биотехнологии РАН Игорь Синельников.

Как ошибка в номере специальности определила карьерный путь
Игорь Синельников поделился с «Рамблером» своей историей, как он открыл для себя мир биотехнологий. Любовь к профессии у химика не родилась с первого взгляда, а в мир биотехнологий он попал волею судьбы. Всегда любил химию и планировал поступать на «фундаментальную и прикладную химию», но при поступлении ошибся в номере специальности и указал биотехнологию в качестве приоритетного направления. Так по чистой случайности Игорь стал студентом Северного (Арктического) федерального университета имени М.В. Ломоносова в городе Архангельске.
«Изначально я крайне скептически относился к профессии. Думал, что биотехнология ограничивается варкой пива и созданием йогуртов. Однако в процессе учёбы осознал: биотехнология — это огромный мир, в котором различные дисциплины переплетаются для того, чтобы поставить биологические процессы на службу людям».
Игорь Синельниковкандидат химических наук, заведующий лабораторией разработки экспрессионных систем ФИЦ Биотехнологии РАН
В обучении Игорю пригодились знания из химии, биологии, физики и смежных направлений.
Сейчас поступить в университет стало легче. Государство берёт на себя существенную часть расходов, а банк помогает реализовать эту возможность.
После учёбы он поступил в аспирантуру ФИЦ Биотехнологии РАН в Москве. Потом четыре года работал в лаборатории биотехнологии ферментов. Там занимался генетической инженерией мицелиальных грибов для получения новых ферментов. Схематично процесс можно объяснить так: грибы синтезируют ферменты, которые можно выделить, очистить и использовать на производствах.
«Это крайне увлекательная отрасль: работа с живыми системами всегда вносит неопределённость в её итоги: ты планируешь один результат, но у микроорганизма может быть совершенно иное "мнение" по этому вопросу», — подчёркивает учёный.
Разработки в области биотехнологий востребованы в промышленности и сельском хозяйстве. Например, создание штаммов, продуцирующих два фермента одновременно, помогают сельскохозяйственным животным лучше переваривать корма на основе зерновых и бобовых. Оптимизированные ферментные препараты используют для обработки плодово-ягодного сырья, чтобы ускорять процессы производства.
Сейчас Игорь Синельников продолжает углубляться в биотехнологии, он возглавляет лабораторию, которая занимается разработкой продуцентов ферментов для нужд пищевой промышленности.
«Сейчас деятельность нашей лаборатории сфокусирована на разработке пищевых ферментов на основе грибов Aspergillus, в частности ферментов для молочной промышленности».
Игорь Синельниковкандидат химических наук, заведующий лабораторией разработки экспрессионных систем ФИЦ Биотехнологии РАН
Ферменты используют, например, для свёртывания молока, для производства безлактозных молочных продуктов. Есть ферменты, которые расщепляют лактозу на глюкозу и галактозу, что позволяет снизить содержание лактозы в молоке и получить продукт для людей с её непереносимостью.

Лабораторные исследования — это целый мир со своими правилами и вызовами. Чтобы добиться желаемого результата, нужно много попыток и времени. Биотехнолог — профессия не для тех, кто любит быстрые результаты и много суеты. Как отмечает Игорь Синельников, биотехнологи работают с живой средой, часто непредсказуемой. Результаты могут быть такими, что ты даже не мог предположить. В этой профессии нужно иметь огромное любопытство, стойкость характера и целеустремлённость.
«Биотехнология, как и любое другое научное направление, состоит из 90% ошибок и 10% успеха», — подчёркивает Игорь Синельников.

День биотехнолога — 2025: когда отмечают, кого поздравляют
Что ещё делают биотехнологи
В сфере биотехнологий много различных областей исследования:
- генетическая инженерия и геномика;
- клеточная биотехнология;
- молекулярная биотехнология;
- биофармацевтика;
- агробиотехнология;
- экологическая биотехнология.
Разработки биотехнологов часто способны по-настоящему удивить. Например, в 2024 году на встрече глав академий наук стран БРИКС российские учёные из Института общей генетики им. Н.И. Вавилова совместно с коллегами из ряда других ведущих российских научно-исследовательских организаций представили доклад о своей разработке. Их проект предполагает создание продуктов питания из воздуха. Разработка заключается в создании микробиологических производств для получения новых продуктов питания из неорганических веществ, которые содержатся в окружающей среде — земле, воде и воздухе.
Канадские учёные из компании Hyperstealth Biotechnology в 2019 году разработали новейший маскировочный материал Quantum Stealth, из которого можно сделать плащ-невидимку. Материал способен делать невидимыми находящиеся за ним предметы любого размера: не только физически, но также в инфракрасной, ультрафиолетовой и тепловой сигнатуре.
Плюсы работы биотехнолога
- Социальная значимость профессии. Без биотехнологов невозможно развитие современной медицины, сельского хозяйства, экологии, промышленности. Они обеспечивают продовольственную безопасность страны. Их разработки спасают жизни людей и улучшают качество жизни.
- Научная новизна и инновации. Работа связана с передовыми технологиями, открытием новых биологических механизмов и разработкой инновационных продуктов. Биотехнологи оказываются причастными к важным открытиям планетарного масштаба.
- Перспективы профессионального развития. С каждым годом спрос на биотехнологов растёт. В 2024 году президент России Владимир Путин определил биотехнологии как один из приоритетов развития науки в России и подписал указ о приоритетных направлениях научно-технологического развития страны.
- Многогранность профессии, постоянное изучение нового. Биотехнологи непрерывно обучаются новым методам и технологиям и находятся в постоянном взаимодействии с учёными и инженерами.
«Один из неоспоримых плюсов для меня — это постоянное развитие. В научную организацию, где я сейчас работаю, обращается множество людей с самыми разнообразными задачами. Это постоянно погружает меня в новые сферы человеческой деятельности. Эта профессия точно не даст вам закостенеть умом!»
Игорь Синельниковкандидат химических наук, заведующий лабораторией разработки экспрессионных систем ФИЦ Биотехнологии РАН
С какими трудностями сталкиваются биотехнологи
- Технические и технологические ограничения. Необходимость использования дорогостоящего и сложного оборудования, ограниченный доступ к современным технологиям в некоторых регионах.
- Этические и правовые вопросы. Особенно это касается учёных, работающих в сфере генной инженерии и медицины, например использования генетически модифицированных организмов (ГМО).
- Неопределённый результат. В исследованиях и разработках не всегда можно предсказать результаты, так как биотехнолог работает с живыми организмами. Опыт может пойти по другому пути и не обязательно увенчаться успехом.
«Трудности работы в научном направлении связаны в первую очередь со спецификой организации научной деятельности в нашей стране. В российской науке сложно задержаться, если ты не любишь искренне свою профессию: требуется много времени, чтобы, помимо морального удовлетворения, она стала приносить ещё и материальные блага».
Игорь Синельниковкандидат химических наук, заведующий лабораторией разработки экспрессионных систем ФИЦ Биотехнологии РАН

Где учиться, чтобы стать биотехнологом
По данным «Поступи.Онлайн», сегодня можно получить профессию биотехнолога в 160 российских вузах и трёх колледжах. Примеры вузов, которые готовят будущих биотехнологов:
- Российский биотехнологический университет
- МГУ имени М.В. Ломоносова
- Российский национальный исследовательский медицинский университет имени Н.И. Пирогова
- Санкт-Петербургский политехнический университет
- Московский политехнический университет
- Российский химико-технологический университет имени Д.И. Менделеева
- Казанский (Приволжский) федеральный университет
- Московский государственный технический университет имени Н.Э. Баумана
Директор центра трансформации образования Школы управления «Сколково», профессор бизнес-практики Ольга Назайкинская считает важным, чтобы школьники глубоко осваивали естественные науки с большим упором на биологию. Важны также химия, физика и, конечно, математика, поскольку многие профессии биотехнологического направления связаны с работой с большими данными и математическими моделями.
«Для популяризации профессии среди потенциальных абитуриентов важно развивать представление о том, что биотехнологии работают на стыке естественных наук и инженерии, а значит, позволяют создавать новый мир. Это новая индустрия, в которой можно разработать уникальные продукты и технологии, меняющие жизнь человека. Государство оказывает поддержку этим направлениям, а значит, будет расти и количество бюджетных мест, и грантовая поддержка исследований».
Ольга Назайкинскаядиректор центра трансформации образования Школы управления «Сколково», профессор бизнес-практики
В новом рейтинге 156 российских вузов признаны лучшими в мире
Сколько зарабатывают биотехнологи
Зарплата биотехнолога зависит от различных факторов:
- опыта специалиста;
- квалификации;
- должности;
- отрасли и сферы деятельности;
- специфики работы;
- региона;
- места работы, типа учреждения.
По данным сайта Dream Job, средняя зарплата биотехнолога в России — 100 000 рублей. Зарплата часто зависит от должности:
- младший специалист, инженер с минимальным стажем работы получает от 40 000 до 70 000 рублей в месяц;
- лаборанты — около 60 000 рублей;
- старший специалист — от 80 000 рублей;
- ведущий специалист — от 100 000–120 000 рублей;
- руководитель направления — более 150 000 рублей в месяц.

Главное
- Биотехнология — синергия естествознания и программирования, объединяющая химию, биологию, физику и другие дисциплины, чтобы решать практические задачи.
- Профессия биотехнолога подразумевает работу с живыми системами, что вносит неопределённость и требует постоянного поиска решений.
- Биотехнология востребована в промышленности и сельском хозяйстве, например в разработке ферментов для улучшения процессов переработки и кормления животных.
- Создание новых микроорганизмов и ферментов играет ключевую роль в пищевой промышленности, включая производство безлактозных продуктов.
- Карьерный путь в биотехнологии может быть непредсказуемым и захватывающим, сочетая научные исследования и прикладные технологии.
Не только для учёных: 5 веских аргументов поступить в аспирантуру в 2025 году

